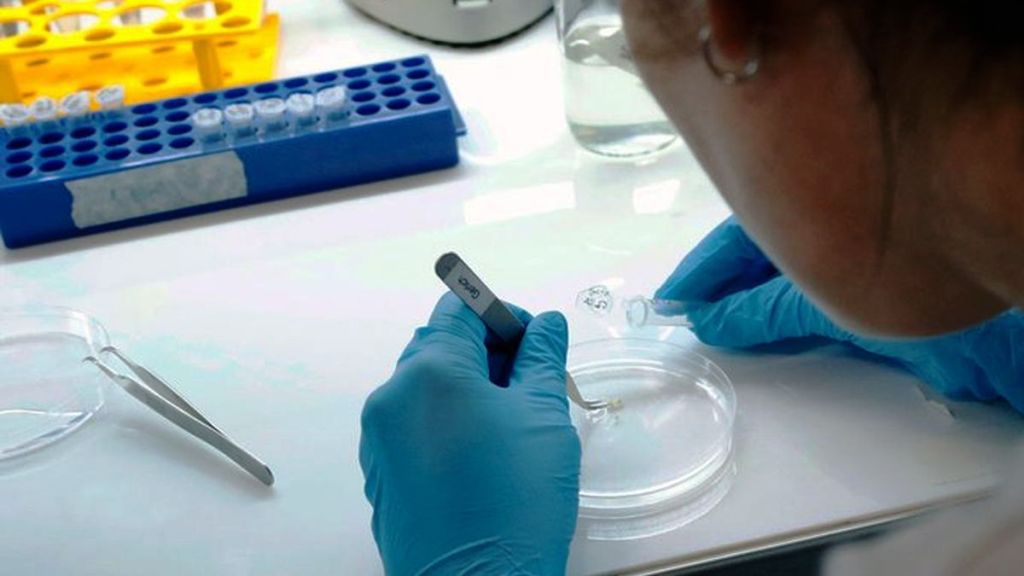

Johnson & Johnson confirmó que su vacuna contra el Covid-19 obtuvo resultados positivos en los voluntarios que formaron parte de su etapa inicial, generando una fuerte respuesta inmune contra la enfermedad.
Basada en estos resultados, la compañía comenzó el pasado miércoles la tercera y última fase de pruebas necesarias antes de solicitar la aprobación de la vacuna. El estudio cuenta con la mayor cantidad de voluntarios para un proceso de esta naturaleza: son 60.000, el doble de la cantidad que participan en aquellos llevados a cabo por otros laboratorios, y están distribuidos en 215 locaciones a lo largo de 8 países: EEUU, Sudáfrica, Argentina, Brasil, Chile, Colombia, México y Perú.
A diferencia de otras candidatas, la posible vacuna de Johnson & Johnson busca generar inmunidad con una sola dosis, lo que podría facilitar su transporte y distribución de ser aprobada, además de disminuir su costo.
Los científicos indicaron que 29 días después de la vacunación el 98 por ciento de los participantes de quienes hubo datos disponibles para realizar el análisis provisional presentaron anticuerpos neutralizantes, que defienden a las células de los patógenos. Los resultados, divulgados en el sitio web médico medRxiv, aún no han sido revisados por pares, un proceso usual en este tipo de publicaciones.
Los resultados indicaron que en los participantes mayores de 65 años, la tasa de reacciones adversas como la fatiga y los dolores musculares fue del 36 por ciento, una cifra sustancialmente inferior al 64 por ciento observado en los participantes más jóvenes. Ello sugeriría que la respuesta inmune en el primer grupo podría no ser tan fuerte.
Sin embargo, solo hubo información disponible de 15 personas mayores de 65 años, por lo que los científicos indicaron que es necesario obtener resultados de más voluntarios antes de llegar a conclusiones sobre este aspecto de la vacuna.
La vacuna está basada en un vector recombinante que utiliza un adenovirus humano (el virus responsable del resfriado común) para expresar la proteína del SARS-CoV-2 en las células. El vector de adenovirus usado se ha modificado para que ya no se pueda replicar en humanos y causar enfermedad.
La compañía ya había comprobado que la vacuna produjo resultados positivos macacos y proporcionó una protección completa o casi completa contra la infección por virus en los pulmones y la nariz después de que fueran expuestos al SARS-CoV-2, el virus que causa el Covid-19. Anthony Fauci, el principal epidemiólogo de la Casa Blanca, ha asegurado que la vacuna es “prometedora”.
Johnson & Johnson indicó que espera tener los resultados finales de sus pruebas para finales de este año o principios del próximo. No obstante, y al igual que lo han hecho otras candidatas prometedoras, la compañía ya ha comenzado la producción en masa de la vacuna para poder distribuirla de manera inmediata en caso de ser aprobada. La compañía planea fabricar hasta mil millones de dosis en 2021, dijo Paul Stoffels, director científico de la empresa.